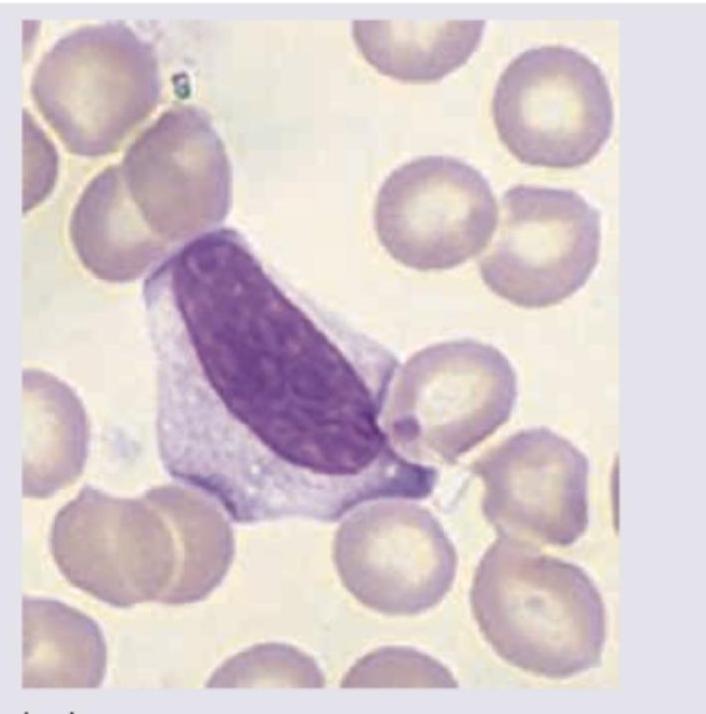
Image for question 361
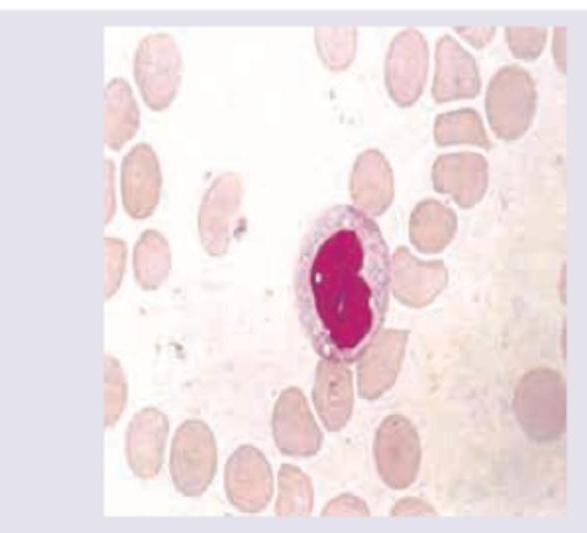
Image for question 364

Enter your email to get your 85% OFF code and unlock the full NEET PG question bank on the app.
The following cell type is seen in peripheral smear of a patient with membrane over the tonsils. All can be used in treatment except?
A 1-year-old unimmunised child with HbsAg positivity is having following skin lesions. What is the diagnosis?

A child presents with low grade fever for 5 days, joint pain in large joints and palpable purpuric rash on lower extremities and buttocks. The most probable diagnosis is:
A 12-year-old child presents with fever, sore throat for 3 days and posterior cervical lymphadenopathy. Peripheral smear was performed. Diagnosis is?
Which of the following statements are correct regarding vaccination routes for children? I. Hepatitis B vaccine given in deltoid region has reduced efficacy II. Two vaccines may be given in the same thigh, but separated by 1 inch III. Separate sites are used when administering a vaccine and an immunoglobulin IV. Two intramuscular vaccines should never be given on the same day Select the answer using the code given below:
All cases of severe measles and all cases of measles in areas with high case fatality rate need to be treated with which of the following vitamins?
In measles, when do the Koplik's spots appear?
Varicella-Zoster Immunoglobulin (VZIG) is NOT recommended for which of the exposed susceptible individuals?
The classical triad of congenital defects in Congenital Rubella Syndrome include which of the following? 1. Hydrocephalus 2. Deafness 3. Cardiac malformations 4. Cataract
Hepatitis B vaccine administered at birth is
Vaccine-Preventable Diseases
Practice Questions
Immunization Schedule
Practice Questions
Common Childhood Infections
Practice Questions
Pediatric HIV
Practice Questions
Congenital Infections
Practice Questions
Fever in Infants and Children
Practice Questions
Meningitis and Encephalitis
Practice Questions
Respiratory Tract Infections
Practice Questions
Gastrointestinal Infections
Practice Questions
Parasitic Infections
Practice Questions
Tuberculosis in Children
Practice Questions
Opportunistic Infections
Practice Questions
Get full access to all questions, explanations, and performance tracking.
Scan to download app